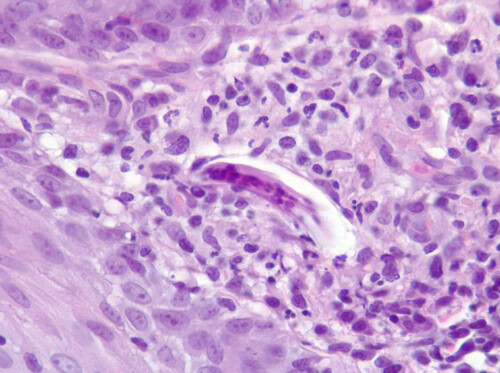
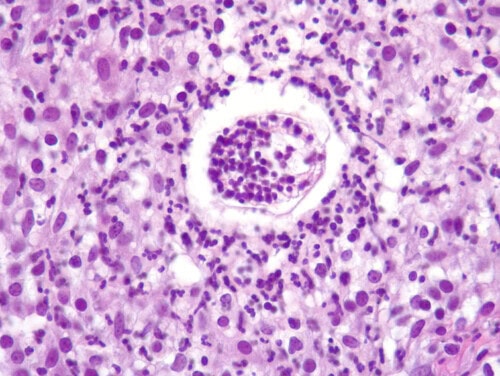

Une chienne Husky de 7,5 ans développe une dermatose prurigineuse chronique sur 3 ans avec lésions érythémateuses, pustuleuses et croûteuses. Les biopsies révèlent des pyogranulomes dermiques contenant des larves de nématodes et des morules parasitaires, orientant vers une nématodose cutanée rare nécessitant un diagnostic différentiel approfondi entre plusieurs espèces parasitaires. Cette observation clinique illustre la complexité diagnostique de ces dermatoses.
Jean-Charles HUSSON
Juillet 2025
Avertissement
Le cas clinique présenté est un cas de dermatopathologie. Aussi, l’anamnèse, l’examen clinique, l’examen dermatologique et les examens complémentaires réalisés, se limiteront à un résumé des données fournies par le vétérinaire ayant pris en charge l’animal.
Commémoratifs
Un chien Husky femelle de 7,5 ans est présentée en consultation de dermatologie pour une dermatose prurigineuse chronique évoluant depuis 3 ans. La dermatose s’est manifestée initialement par une pyodermite au niveau du dos. Le prurit est primaire, d’intensité ++/+++ et corticosensible (l’animal reçoit des corticoïdes une semaine par mois pour des troubles pulmonaires dont la nature n’est pas précisée). Le prurit est particulièrement important au niveau des pieds. L’animal vit au contact d’un autre chien et de deux chats qui ne présentent pas de signes dermatologiques. Pas de contagion humaine rapportée.
Examen dermatologique
La chienne présente une très sévère dermatose se manifestant par des lésions érythémateuses pustuleuses et croûteuses au niveau du chanfrein, des coudes, du ventre et surtout à la base du dos. La peau montre secondairement une alopécie, une hyperpigmentation, une lichénification.

Diagnostic différentiel
Face à ce tableau dermatologique atypique probablement modifié de manière significative par la chronicité (3 ans) voire des surinfections, des hypothèses de dermatose améliorée par le zinc, de pemphigus foliacé et de mycosis fongoïde sont envisagées.
Examens complémentaires
De précédents dosages hormonaux n’ont pas mis en évidence d’hypothyroïdie.
Des prélèvements pour culture bactériologique et antibiogramme sont réalisés.
Des biopsies cutanées (5) sont également réalisées.
Examen histologique
L’aspect histologique est tout à fait inhabituel avec une certaine hétérogénéité des lésions.
Sur deux biopsies, les lésions restent modérées et peu spécifiques. l’épiderme est acanthosique, spongiotique, hypergranuleux, ortho- à parakératosique, parsemé de quelques squames-croûtes avec une inflammation dermique périvasculaire superficielle à périannexielle à base de lymphocytes et de plasmocytes. Les annexes sont bien en place et peu modifiées.
Sur cette miniature on observe l’hyperplasie de l’épiderme, parsemé d’une croûte et une inflammation peu spécifique du derme, les annexes étant encore présentes.
Les autres trois biopsies au contraire montrent un tégument velu sévèrement modifié. Les unités folliculo-sébacées ont complètement disparu. Les muscles arrecteurs sont encore présents. On note encore quelques glandes sudorales apocrines. Le derme est ponctué de foyers inflammatoires parfois coalescents jusqu’à la jonction dermo-hypodermique. Ces foyers sont formés principalement par des macrophages épithélioïdes et des neutrophiles, constituant des pyogranulomes. Ces pyogranulomes peuvent être hémorragiques ou contenir des lipides. La localisation de ces pyogranulomes est parfois compatible avec des traces de furonculose. Le derme montre une fibrose et une fibroplasie horizontales (fibrose cicatricielle).
Sur cette miniature on constate une disparition des unités pilo-sébacées au profit d’une inflammation nodulaire multifocale du derme et de la jonction dermo-hypodermique (granulomes et pyogranulomes parfois centrés sur des lipides) et d’un fond de fibrose cicatricielle. Les lésions les plus superficielles apparaissent hémorragiques.
Cette miniature l’aspect est assez semblable à précédemment. Les lésions sont particulièrement hémorragique en surface et l’épiderme est localement décollé et croûteux.
Détail de multiples granulomes et pyogranulomes coalescents visibles à la jonction dermo-hypodermique. Noter la petite vacuole lipidique claire au centre de certains d’entre eux.
Détail d’une lésion pyogranulomateuse hémorragique développée dans le derme superficiel/moyen, probablement en lieu et place d’une unité pilo-sébacée (probable ancien furoncle remanié). Notez la fibrose du derme perceptible dans le coin inférieur droit.
Détail du derme autour des lésions inflammatoires et caractérisé par un dépôt de collagène (fibrose) orienté horizontalement associé une prolifération des fibroblastes (fibroplasie) elle-même orientée horizontalement, caractéristiques d’une fibrose cicatricielle.
L’examen plus rapproché des biopsies permet d’identifier deux éléments supplémentaires d’intérêt majeur. Sur une biopsie, à proximité d’une unité pilo-sébacée on observe un élément vermiforme de plusieurs dizaines de micromètres, contenant des noyaux et un tube digestif rudimentaire, compatible avec une larve de nématode. Sur une autre biopsie, dans un pyogranulome, on observe un élément rond de plusieurs dizaines de micromètres, d’aspect syncytial, à cytoplasme clair, contenant de multiples noyaux très sombres, compatible avec une morule, un stade embryonnaire de nématode.
Détail de la larve de nématode observée sur la première miniature, entourée de cellules inflammatoires à proximité d’une unité pilo-sébacée. Notez cet aspect vermiforme, la présence de structures internes et notamment de noyaux, typique d’une larve de nématode.
Détail de la morule parasitaire observée dans un pyogranulome. Notez cette structure ronde, syncytiales, comprenant de nombreux noyaux, complètement différente des cellules et des tissus alentours.
Le différentiel histologique est assez réduit compte tenu de l’observation d’au moins un agent pathogène clairement identifiable comme une larve de nématode et d’un probable autre élément parasitaire visible sous la forme d’une morule. Le différentiel est donc essentiellement celui des nématodes cutanées : Pelodera strongyloides, Uncinaria stenocephala, Ancylostoma caninum, Angiostrongylus vasorum. La visualisation de larves ne permet pas de retenir dans le différentiel des lésions cutanées provoquées par des filaires du genre Dirofilaria pour lesquelles on s’attendrait à voir des formes adultes (D. repens) ou des microfilaires (D. immitis).
Traitement
Suite au diagnostic, l’identification du parasite par différents examens complémentaires (épilations, raclage, coproscopie) est conseillée. Un traitement nématodicide est indiqué.
Compte tenu de la présence de signes respiratoires justifiant une corticothérapie dans les commémoratifs, et de la possibilité d’une angiostrongylose pulmonaire et cutanée, une exploration de la fonction respiratoire et notamment du territoire pulmonaire est indiquée, par imagerie notamment mais également indirectement par coproscopie.
Discussion
Les dermatoses à nématode sont des dermatoses rares et probablement sous-diagnostiquées chez les chiens en France métropolitaine.
La nématodose cutanée la plus fréquemment rencontrée chez le chien est probablement la pélodérose, une infestation cutanée par le nématode rhabditidé Pelodera strongyloides. Cet organisme est un nématode saprophyte libre, que l’on retrouve dans la matière organique humide. Le stade larvaire L3 peut occasionnellement envahir la peau des chiens. Les chiens en contact avec des litières d’herbe ou de terre contaminées développent des lésions cutanées par contact direct, suite à la pénétration des larves dans l’épiderme et les follicules pileux.
Chez le chien atteint de pélodérose, les lésions cutanées se manifestent principalement sous la forme d’un érythème, d’une éruption papuleuse à croûteuse, et d’une alopécie. Des pustules peuvent apparaître et témoigner d’une pyodermite secondaire. Le prurit est généralement intense, mais dans certains cas il n’est pas décrit de démangeaisons.
Les zones touchées correspondent aux surfaces en contact avec une litière contaminée et sont généralement les régions glabres et déclives : parties ventrales (abdomen, thorax), espaces interdigités, périnée, face ventrale de la queue.. Dans certains cas on observe uniquement une atteinte podale : lésions interdigités et coussinets épaissis et fissurés.
Le diagnostic de la pélodérose chez le chien repose sur l’identification des larves de P. strongyloides par raclages cutanés profonds ou trichogrammes, ces derniers pouvant s’avérer plus sensibles d’après une étude récente. L’histopathologie permet rarement de voir directement les larves (faible sensibilité de l’examen dans ce contexte) mais montre des lésions assez stéréotypées secondaires à la pénétration des larves.
Outre la pélodérose, d’autres nématodes peuvent infester la peau des carnivores domestiques. Les espèces les plus fréquemment rapportées sont des nématodes infestant primitivement le tube digestif des chiens et dont les larves peuvent pénétrer la peau : Strongyloides stercoralis (famille des strongyloïdidés), Ancylostoma caninum et Uncinaria stenocephala (famille des ancylostomatidés ou « ankylostomes »).
Dans un rapport de cas d’uncinariose cutanée, l’animal ne présentait que des lésions dermatologiques sans signes digestifs. Ces lésions consistaient en des lésions érythémateuses, alopéciques, papuleuses et croûteuses localisées sur le thorax ventral et l’abdomen ventral avec des coussinets hyperkératosiques et fissurés. Aucune atteinte systémique n’était notée. Le diagnostic a pu être posé grâce à l’histopathologie. L’identification de l’espèce parasitaire a été permise par macération sur biopsie et par identification des œufs en coproscopie.
Dans le cas d’une strongyloïdose le tableau clinique est normalement dominé par les signes digestifs (amaigrissement, diarrhée profuse) voire respiratoires. Les lésions cutanées associées sont considérées comme mineures et transitoires en comparaison et peuvent inclure des éruptions érythémateuses prurigineuses au site de pénétration des larves, ainsi que des lésions serpigineuses appelées larva currens, provenant de la progression des larves dans le derme, notamment sur le périnée et autour de l’anus.
On peut également citer Dirofilaria repens, un nématode filaire transmis par les moustiques, qui se développe chez les chiens (et d’autres mammifères) en formant des nodules sous-cutanés. Son cycle comprend une transmission par piqûre de moustique, avec maturation des larves en adultes dans les tissus sous-cutanés du chien. On peut retrouver les adultes vivant dans des pseudo-kystes ou morts et associés à une panniculite pyogranulomateuse. Cliniquement, l’infection se manifeste souvent par une ou plusieurs masses sous-cutanées molles.
Il a pu être rapporté des signes cutanés anecdotiques chez certains chiens infestés par Dirofilaria immitis sous la forme d’une dermatite prurigineuse, papuleuse à nodulaire, avec croûtes et ulcérations, imitant une gale sarcoptique, touchant la tête, le tronc et les extrémités. Histologiquement on peut observer une dermatite pyogranulomateuse plus ou moins éosinophilique centrée sur les vaisseaux, avec des microfilaires au sein des lésions.
Enfin on peut mentionner un joli rapport de cas publié par une équipe française faisant état d’un chien Braque de Weimar femelle de 3 ans présenté pour des lésions cutanées localisées (plaques croûteuses et érythémateuses sur le chanfrein et les pavillons auriculaires, pododermatite avec érosions sur un doigt). Les raclages et les cultures fongiques étaient négatifs. L’examen histopathologique des biopsies cutanées montrait des granulomes et pyogranulomes cutanés associés à des larves de nématodes. La PCR sur biopsies cutanées et le test de Baermann sur les selles ont montré la présence de nématodes de l’espèce Angiostrongylus vasorum.
Ce cas est particulièrement original et intéressant car contrairement aux cas classiques d’infestation par Angiostrongylus vasorum (où les signes respiratoires dominent), ce chien présentait uniquement des lésions cutanées sans signes respiratoires associés. D’après les auteurs les larves ont vraisemblablement atteint la peau via la circulation sanguine depuis le territoire pulmonaire. En effet, l’histopathologie des biopsies cutanées montrait des éléments parasitaires compatibles avec des larves dans les granulomes dermiques et dans la lumière de certains vaisseaux sanguins, ce qui suggère une infestation par voie hématogène.
Conclusion
Le diagnostic des nématodoses cutanées chez le chien est souvent complexe en raison de signes dermatologiques peu spécifiques et protéiformes : prurit, érythème, papules, alopécie et croûtes peuvent facilement prêter à confusion avec d’autres dermatoses courantes comme une pyodermite superficielle, une dermatophytose, une hypersensibilité cutanée… De plus ces parasitoses cutanées ne sont généralement pas envisagées en première intention par le vétérinaire car elles sont rarement rencontrées et diagnostiquées. Les biopsies cutanées peuvent jouer un rôle clé dans la mise en évidence des larves, permettant d’orienter le diagnostic vers une origine parasitaire. Toutefois, l’examen histopathologique souffre d’une carence importante de sensibilité, car les larves peuvent être peu nombreuses, mal distribuées dans les tissus ou même absentes de la zone prélevée, ne permettant que rarement une observation directe. Cela souligne la nécessité de coupler l’histologie à d’autres examens complémentaires (raclages, coproscopie, PCR) et surtout de garder l’esprit ouvert lors de dermatose de présentation inhabituelle.
Références bibliographiques
Căpitan, R.G.M. & Noli, C. (2017). Trichoscopic diagnosis of cutaneous Pelodera strongyloides infestation in a dog. Veterinary Dermatology, 28(4), 413–e100. https://doi.org/10.1111/vde.12432
Cavana, P., Bensignor, E., Blot, S., Carlus, M., Chermette, R., Crosaz, O., Grimm, F., Hurion, M., Jeandel, A., & Polack, B. (2015). Nematode dermatitis due to Angiostrongylus vasorum infection in a dog. Veterinary Dermatology, 26(4), 293–e65. https://doi.org/10.1111/vde.12215
Chu, S., Myers, S. L., Wagner, B., & Snead, E. C. (2013). Hookworm dermatitis due to Uncinaria stenocephala in a dog from Saskatchewan. Canadian Veterinary Journal, 54(8), 743–747. PMID: 24155473.
Gross, T. L., Ihrke, P. J., Walder, E. J., & Affolter, V. K. (2005). Skin Diseases of the Dog and Cat: Clinical and Histopathologic Diagnosis (2nd ed.). Oxford: Blackwell Science. ISBN 978-0-632-06452-6.
Maxie, M. G. (Ed.). (2015). Jubb, Kennedy, and Palmer’s Pathology of Domestic Animals (6th ed.). Vol. 1-3. Elsevier.
MSD Manual. Maladies infectieuses : Strongyloïdose [Internet]. [cité 2025 mai 28]. Disponible sur : https://www.msdmanuals.com/fr/professional/maladies-infectieuses/nématodes-vers-ronds/strongyloïdose